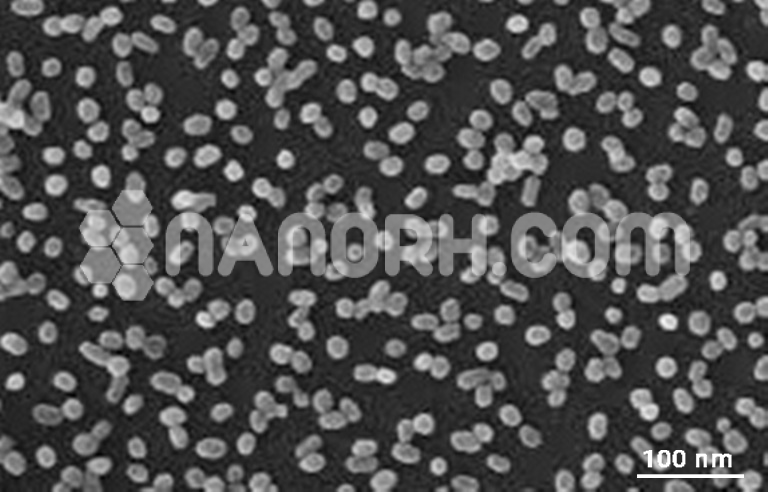
Phosphotungstic Acid Phosphotungstic Acid

| Phosphotungstic Acid | |
| Product No | NRE-31080 |
| CAS | 12076-99-1 |
| Purity | 99% |
| APS | <50 µm (can be customized) |
| Molecular Weight | 2880.05g/mol |
| Density | 960 kg/m3 |
| Color | White |
| Molecular Formula | H3[P(W3O10)4] • xH2O |
| Melting Point | 95°C |
| Boiling Point | NA |
Phosphotungstic Acid